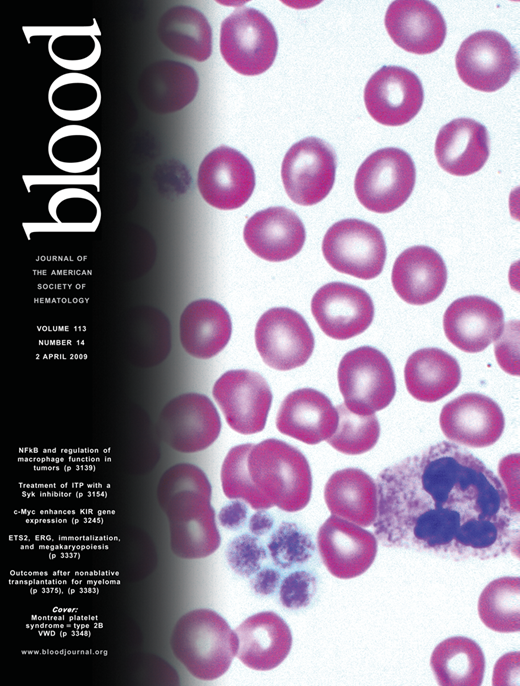

Abstract
The core-binding factor (CBF) is a master regulator of developmental and differentiation programs, and CBF alterations are frequently associated with acute leukemia. The role of the CBF member RUNX2 in hematopoiesis is poorly understood. Genetic evidence suggests that deregulation of Runx2 may cause myeloid leukemia in mice expressing the fusion oncogene Cbfb-MYH11. In this study, we show that sustained expression of Runx2 modulates Cbfβ-smooth muscle myosin heavy chain (SMMHC)–mediated myeloid leukemia development. Expression of Runx2 is high in the hematopoietic stem cell compartment and decreases during myeloid differentiation. Sustained Runx2 expression hinders myeloid progenitor differentiation capacity and represses expression of CBF targets Csf1R, Mpo, Cebpd, the cell cycle inhibitor Cdkn1a, and myeloid markers Cebpa and Gfi1. In addition, full-length Runx2 cooperates with Cbfβ-SMMHC in leukemia development in transplantation assays. Furthermore, we show that the nuclear matrix–targeting signal and DNA-binding runt-homology domain of Runx2 are essential for its leukemogenic activity. Conversely, Runx2 haplo-insufficiency delays the onset and reduces the incidence of acute myeloid leukemia. Together, these results indicate that Runx2 is expressed in the stem cell compartment, interferes with differentiation and represses CBF targets in the myeloid compartment, and modulates the leukemogenic function of Cbfβ-SMMHC in mouse leukemia.
Introduction
Leukemia arises from the accumulation of genetic alterations that reprogram cellular pathways regulating survival and differentiation. The core-binding factor (CBF) is a heterodimeric transcription factor that consists of a DNA-binding α subunit (encoded by RUNX1, RUNX2, or RUNX3) and a non–DNA-binding β subunit (encoded by CBFB). The RUNX proteins contain a Runt-homology domain (RHD) required for DNA binding and binding with CBFβ that increases the DNA-binding affinity of RUNX and is critical for its transactivation function.1,2 In addition, members of the RUNX family share homology in multiple functional domains, including a nuclear-matrix targeting signal (NMTS) and transactivation domain (TAD).3 Despite the overall similarity, the specificity of each RUNX protein function is not clear. Runx1 and Cbfβ are essential for the emergence of the embryonic hematopoietic stem cells (HSCs) from the endothelium and development of embryonic definitive hematopoiesis.4-7 The expression of Runx2 is important for bone development as intramembranous and endochondral ossification is blocked in the absence of Runx2.8
The CBF transcription factors can function as either tumor suppressors or oncogenes depending on the cell context.9 In human acute myeloid leukemia (AML), CBF is a common target of recurrent chromosomal translocations, including t(8:21) and inv(16)(p13;q22), which give rise to fusion proteins acting as dominant inhibitors of CBF function.10,11 In addition to chromosomal translocations, somatic point mutations in RUNX1 have been identified in de novo AML and in therapy-related myelodysplastic syndrome and AML.12-15
The CBF factors are also known to act as oncogenes. For example, the genomic amplification of the RUNX1 locus has been found in a subset of childhood B-cell acute lymphoblastic leukemias and in a small number of myeloid leukemia cases.16-22 Furthermore, overexpression of RUNX1 can be detected in up to 44% of acute lymphoblastic leukemia patients.23 In the mouse, Runx2 was identified as a frequent target of retroviral insertional activation in T-cell lymphomas,24,25 and expression of Runx2 from the CD2-Runx2 transgene induces lymphoma in collaboration with MYC.26 In addition, Runx1 and Runx3 have been identified as common targets of retroviral insertional activation in murine lymphoma models,27-30 and increased dosage of Runx1 has been shown to act as a positive modulator of myeloid leukemias in BXH2 mice.31,32
The chromosome inversion inv(16)(p13;q22) is present in approximately 12% of human AML samples and creates the fusion gene CBFB-MYH11, which encodes the leukemia fusion protein CBFβ-smooth muscle myosin heavy chain (SMMHC). This fusion protein is thought to act as a dominant negative repressor of CBF function. Previous studies have shown that it hinders embryonic definitive hematopoiesis in Cbfb-MYH11 knock-in mice11 and multilineage differentiation of HSCs during adult hematopoiesis and predisposes mice to the development of AML.33,34 We have previously identified Runx2 as a common insertional site in a retrovirus insertional mutagenesis screen performed to identify genes that cooperate with Cbfβ-SMMHC in AML development,35 with 3 independent insertions that mapped within the intron 5. Given the oncogenic role of RUNX2 and our genetic data, we hypothesize that sustained levels of Runx2 can modulate the leukemogenic function of Cbfβ-SMMHC. In this study, we tested this hypothesis using genetically modified hematopoietic progenitors (HPs) and a murine model of CBFβ-SMMHC-induced AML. We demonstrate that sustained Runx2 expression cooperates with Cbfβ-SMMHC in AML formation in the mice with a medium latency of 17 weeks. Conversely, haploid insufficiency of Runx2 delays the onset and reduces the incidence of Cbfβ-SMMHC–mediated leukemia. In addition, we show in transplantation assays that Runx2 oncogenicity depends on its DNA-binding and NMTS domains. We further show that ectopic expression of Runx2 in bone marrow (BM) progenitor cells hinders proliferation of myeloid progenitors, directly represses expression of CBF targets Mpo, Cebpd, Csf1R, and Cdkn1a, and inhibits expression of myeloid genes Cebpa and Gfi1.
Methods
Mice and statistics
Heterozygous Runx2+/−8 or heterozygous Runx2+/ΔC36 mice were crossed with Cbfb+/56M mice and the Mx1-Cre transgenic mice (provided by Klaus Rajewsky, Harvard University,37 Cambridge, MA), and experiments were performed in mixed strain (F1/129SvEv; B6D2F1/J) and groups compared with littermates of the same background. For induction, Cbfb56M/+/Mx1Cre+/Runx2+/− or Cbfb56M/+/Mx1Cre+/ Runx2+/ΔC mice were injected intraperitoneally every other day with 3 doses of polyinosine-polycytosine (pIpC; 200 μg/dose; Sigma-Aldrich, St Louis, MO) at 4 weeks of age as previously described.34 All mice were treated in accordance with federal and state government guidelines, and the University of Massachusetts Medical School Institutional Animal Care and Use Committee. Statistical analyses were performed using the R software for statistical computing (www.r-project.org).
BM transduction transplantation assays
Cbfb-MYH11 expression in Mx1Cre;Cbfb56M/+ BM cells from 129SvEv mice was induced by 3 doses of pIpC (Sigma-Aldrich). One week after induction, mice were treated with 5-fluorouracil (5-FU; 150 mg/kg) 6 days before isolation of BM cells. Harvested BM cells were maintained in RPMI media supplemented with 20% heat-inactivated fetal bovine serum (Invitrogen, Carlsbad, CA), 6 ng/mL interleukin (IL)-3, 10 ng/mL IL-6, and 10 ng/mL stem cell factor (PeproTech, Rocky Hill, NJ) and transduced with MSCV-IRES-GFP-(MIG) based retroviruses in the presence of 5 μg/mL polybrene (American Bioanalytical, Natick, MA) by 2 serial spinoculation at 2500 rpm for 90 minutes followed by incubation at 37°C for 2 hours with a 24-hour interval. After the second infection, 5 × 105 cells were transplanted intravenously into sublethally irradiated (650 cGy) 6-week-old wild-type 129SvEv (Taconic Farms, Germantown, NY). Mice were monitored for 6 months for signs of leukemia.
In vitro differentiation and serial-replating assays
Mx1Cre+/Cbfb+/56M or Cbfb+/56M mice were treated with 3 doses of pIpC every other day. One week later, mice were treated with 5-FU (150 mg/kg), and HPs isolated from BM were transduced with MIG or MIG-Runx2 retroviruses as described in “BM transduction transplantation assays.” Green fluorescent protein (GFP)+ cells were sorted, and 104 cells plated in triplicate in methylcellulose media containing stem cell factor, IL-3, IL-6, and erythropoietin (M3434, StemCell Technologies, Vancouver, BC). Total numbers of myeloid colony-forming units (CFU) and cells per plate were counted after 7 days of culture in 5% CO2 at 37°C. For serial replating, cells were recovered, counted, and pooled, and 104 cells were replated in triplicate for subsequent culture.
Flow cytometry and cell sorting
Peripheral blood was extracted from the retro-orbital sinus, followed by lysis of red blood cells with red blood cell lysis solution (Puregene; Gentra Systems, Minneapolis, MN), and the white blood cell pellet was resuspended in phosphate-buffered saline with 0.5% bovine serum albumin. BM cells isolated from femurs and tibias were resuspended in staining media (phosphate-buffered saline; 0.5% bovine serum albumin) and treated 10 minutes on ice with 2.4G2 Fc block (BD Biosciences, San Jose, CA). Cells were incubated for 20 minutes on ice with primary antibodies and washed, and biotin-stained cells were incubated with secondary reagents for 15 minutes on ice. Primary antibodies included c-kit (2B8)-allophycocyannin (APC), Sca-1 (E13-161.7) fluorescein iothiocyanate (FITC) or -phycoerythrin (PE), Flt3 (A2F10.1)-PE, CD34 (RAM34)-PE or APC, CD16/32 FcγRΙΙΙ/ΙΙ (2.4G2)-FITC, B220 (RA3-6B2), CD3 (17A2), CD4 (L3T4), CD8 (53-6.7), Gr-1 (R86-8C5), Mac-1 (M1/70), Ter119 (Ly-76) conjugated with biotin, FITC, PE, APC, or peridinin chlorophyll protein-Cy5.5 (BD Biosciences; eBioscience, San Diego, CA). Secondary reagents used were streptavidin-APC or peridinin chlorophyll protein-Cy5.5 (BD Biosciences). Flow cytometry was performed on a 3-laser 9-detector LSR II (BD Biosciences) or a 3-laser, 7-detector DIVA FACSVantage and analyzed with FlowJo software (TreeStar, Ashland, OR). Sorting was performed using a 3-laser, 7-detector DIVA FACSVantage (BD Biosciences) or a 3-laser 7-detector MoFlo (Dako Colorado, Fort Collins, CO). The purity of sorted populations was 91% to 95%. Phenotypic progenitor populations were defined as HSCs (Lin−/Sca-1hi/ckithi), common myeloid progenitor (CMP; Lin−/c-kithi/Sca-1−/CD34+/CD16/32lo), granulocytic-macrophage progenitor (GMP; Lin−/c-kithi/Sca-1−/CD34+/CD16/32hi), and megakaryocyte-erythroid progenitor (MEP; Lin−/c-kithi/Sca-1−/CD34−/CD16/32lo) as previously described.38-41
Histology and cytology analyses
Tissue samples (spleen, liver, tibia, lung, thymus, lymph nodes, brain, epithelial) collected from leukemic mice were fixed in 10% buffered formalin, embedded in paraffin, and sectioned specimens were stained with hematoxylin and eosin. For cytologic and morphologic analysis, cyto-centrifuged preparations were stained with Wright-Giemsa (Fisher Scientific, Pittsburgh, PA) according to the manufacturer's instructions. Images were taken using a Zeiss Axioskop 40 microscope (Carl Zeiss, Jena, Germany) with 40× or 100× (using Zeiss Immersol 518N oil) lenses, or Zeiss Stemi 2000-C stereoscope at 12× magnification. The images were acquired with a Zeiss AxioCam MRc camera and MR-Green acquisition software.
Chromatin immunoprecipitation assays
Approximately 1.5 × 106 AML cells were subjected to chromatin immunoprecipitation assay using 3 μg of a rabbit polyclonal antibody raised against Runx2 (Santa Cruz Biotechnology, Santa Cruz, CA; sc-10758, clone M 70) or normal rabbit anti-IgG. Chromatin immunoprecipitation was performed essentially as described.42 Briefly, 5 μL of the precipitated DNA was subjected to quantitative polymerase chain reaction (PCR) using indicated gene specific primers. Primers for negative controls, Phox and Cdc6 3′-untranslated region have been previously reported.42 All other primers were validated using mouse genomic DNA from embryonic stem cells and primers with single dissociation peaks were selected. These primers are: Cdkn1aF 5′-GCGGCTGTTTTTCTTGGTAG-3′ and Cdkn1aR 5′-AGACGAGGAAAGCAGTTCCA-3′, MpoF 5′-TTGCTCCTTAGCCAAGATGG-3′ and MpoR 5′-AGAGAAGGACCCAGAGCTGA-3′, Csf1rF 5′-AGAAGAAGGCAAGGGAATGA-3′ and Csf1rR 5′-GCATAGTCCGTTTGCTGTGA-3′, and CebpdF 5′-CCAAGAAGAAATGCCAGAGC-3′ and CebpdR 5′-CGAACCCTCTCCAGCTACAC-3′.
Quantitative PCR analysis
GFP-positive HPs were isolated from 5-FU-treated wild-type (control) or induced Mx1Cre+/Cbfb+/56M BM transduced with respective retroviruses, as described in “BM transduction transplantation assays.” The RNA from sorted cells was extracted with Trizol reagent (Invitrogen) or RNeasy Micro Kit (Qiagen, Valencia, CA) according to the manufacturer's protocol. First-strand cDNA was generated using 200 U SuperScript III reverse transcriptase (Invitrogen) and 0.5 μg oligo dT primer in a 20-μL reaction. The quantitative PCR was performed using SYBR Green PCR master mix (Applied Biosystems, Foster City, CA; or Roche Diagnostics, Basel, Switzerland) containing 0.2 μM gene-specific primers and detected in ABI PRISM 7000 sequence detection system (Applied Biosystems) or LightCycler 480 system (Roche Diagnostics) according to the manufacturer's instructions. Detection of alternative promoter isoforms is performed using isoform specific primers, including distal promoter primers Rx2P1f: 5′-ATGCTTCATTCGCCTCACAAAC-3′ and Rx2P1r: 5′-GCTCACGTCGCTCATCTTG-3′; proximal promoter primers Rx2P2f: 5′-ACTTCGCTAACTTGTGGCTG-3′ and Rx2P2f: 5′-GCTCACGTCGCTCATCTTG-3′. Total Runx2 levels were detected using Rx2f: 5′-CACTGGCGGTGCAACAAGA-3′ and Rx2r: 5′-TGGTACCTCTCCGAGGGCTACA-3′. Relative expression levels of exon 5 including-Runx2 splice variants were estimated using primers Rx2e5f: 5′-CGCATTCCTCATCCCAGTATG-3′ and Rx2e5f: 5′-AAGACTGTGCCTGCCTGGGA-3′. Other primers used for quantitative PCR include Rx1f: 5′-CCAGCAAGCTGAGGAGCGGCG-3′and Rx1r: 5′-TGACGGTGACCAGAGTG-3′; Mpof: 5′-ATGCAGTGGGGACAGTTTCTG-3′ and Mpor: 5′-GTCGTTGTAGGATCGGTACTG-3′; Cebpdf: 5′-TCGACTTCAGCGCCTACATTG-3′ and Cebpdr: 5′-CGCTTTGTGGTTGCTGTTGA-3′; Cebpaf: 5′-AAAGCCAAGAAGTCGGTGGAC-3′ and Cebpar: 5′-CTTTATCTCGGCTCTTGCGC-3′; Csf1Rf: 5′ GCGATGTGTGAGCAATGGCAGT and Csf1Rr: 5′-AGACCGTTTTGCGTAAGACCTG-3′; Gfi1f: 5′-AGGAGGCACCGAGAGACTCA-3′ and Gfi1r: 5′-GGGAGGCAGGGAAGACATC-3′. Absolute quantitative analysis for Runx1 and Runa2 was performed using serial dilutions of known quantities of plasmid containing the amplicon of interest as standards. Relative expression levels were normalized to that of Actb (Actbf 5′-CCCTAAGGCCAACCGTGAA-3′ and Actbr 5′-CAGCCTGGATGGCTACGTACA-3′) or Hprt (Hprtf 5′-TCCTCCTCAGACCGCTTTT-3′ and Hprtr 5′-CCTGGTTCATCATCGCTAATC-3′).
Results
Runx2 is expressed in the HSC/early HP compartment in BM
Genetic studies have implicated Runx2 in leukemia development in the mouse, including Cbfb-MYH11–associated myeloid leukemia.35 The Runx2 gene generates multiple isoforms, from the distal promoter (P1) upstream of exon1 or the proximal promoter (P2) upstream of exon 2 (Figure 1A). The expression of Runx2 transcript in HPs has not been characterized. We estimated the Runx2 relative expression levels of total Runx2, the isoforms from distal promoter (P1) and proximal promoter (P2), and the isoform including the alternative spliced exon 5 (Ex5; this isoform is critical for Runx2 nuclear transport and function), using quantitative reverse-transcribed (RT)-PCR in sorted HSCs (LSK compartment), CMP, the committed GMP, and MEP compartments (Figure 1B,C). The relative Runx2 expression levels were high in HSCs, decreased to 30% in CMPs, and were minimally detected in committed progenitors GMPs and MEPs. In addition, we performed a standard titration curve for each primer pair to compare expression of P1, P2, and Ex5 isoforms to that of total Runx2. In addition, Runx2 transcript in HSCs was 6-fold higher than that of Runx1 (Figure 1C). These analyses show that Runx2 is expressed in the HSCs/early HP compartment from the proximal promoter, with prevalent representation of exon5 containing Runx2 isoform.
Runx2 expression in BM hematopoietic progenitor cells. (A) Representation of Runx2 gene (top), showing the alternative transcription initiation sites (arrows) from distal promoter (P1) at exon 1 and proximal promoter (P2) at exon 2, with coding exons (gray box) and untranslated sequences (white box). The major Runx2 transcript isoforms from each promoter and the alternative spliced exon 5 are depicted in black boxes (bottom). (B) RELs of Runx2 isoforms (left) in sorted HSCs ( ), CMP (□), GMP (■), and MEP (
), CMP (□), GMP (■), and MEP ( ) cells by quantitative PCR. Transcripts for total Runx2 (Rx2), P1- or P2-specific, and exon 5-containing (Ex5) isoforms. (C) Relative expression levels of Runx2 (Rx2) and Runx1 (Rx1) in sorted HSCs, CMP, GMP, and MEP cells determined by quantitative PCR and normalized to primer bias using limiting dilution correlation curve. (D) Experimental design of in vitro myeloid differentiation assay and serial replating of wild-type (wt) and Cbfb-MYH11-expressing (CM) BM cells infected with empty (MIG) or Runx2-expressing (Runx2) retrovirus; 104 GFP sorted cells were cultured in methylcellulose. (E) Representative photograph of day 7 CFUs comparing wild-type (top) and Cbfb-MYH11-expressing (bottom) BM cells infected with empty (MIG) or Runx2-expressing (Runx2) retrovirus in plating 1. (F) Histogram showing the number of day 7 myeloid CFU in platings 1 (
) cells by quantitative PCR. Transcripts for total Runx2 (Rx2), P1- or P2-specific, and exon 5-containing (Ex5) isoforms. (C) Relative expression levels of Runx2 (Rx2) and Runx1 (Rx1) in sorted HSCs, CMP, GMP, and MEP cells determined by quantitative PCR and normalized to primer bias using limiting dilution correlation curve. (D) Experimental design of in vitro myeloid differentiation assay and serial replating of wild-type (wt) and Cbfb-MYH11-expressing (CM) BM cells infected with empty (MIG) or Runx2-expressing (Runx2) retrovirus; 104 GFP sorted cells were cultured in methylcellulose. (E) Representative photograph of day 7 CFUs comparing wild-type (top) and Cbfb-MYH11-expressing (bottom) BM cells infected with empty (MIG) or Runx2-expressing (Runx2) retrovirus in plating 1. (F) Histogram showing the number of day 7 myeloid CFU in platings 1 ( ), 2 (■), and 3 (□). Data are mean plus or minus SD from at least 2 independent experiments, each in triplicate.
), 2 (■), and 3 (□). Data are mean plus or minus SD from at least 2 independent experiments, each in triplicate.
Runx2 expression in BM hematopoietic progenitor cells. (A) Representation of Runx2 gene (top), showing the alternative transcription initiation sites (arrows) from distal promoter (P1) at exon 1 and proximal promoter (P2) at exon 2, with coding exons (gray box) and untranslated sequences (white box). The major Runx2 transcript isoforms from each promoter and the alternative spliced exon 5 are depicted in black boxes (bottom). (B) RELs of Runx2 isoforms (left) in sorted HSCs ( ), CMP (□), GMP (■), and MEP (
), CMP (□), GMP (■), and MEP ( ) cells by quantitative PCR. Transcripts for total Runx2 (Rx2), P1- or P2-specific, and exon 5-containing (Ex5) isoforms. (C) Relative expression levels of Runx2 (Rx2) and Runx1 (Rx1) in sorted HSCs, CMP, GMP, and MEP cells determined by quantitative PCR and normalized to primer bias using limiting dilution correlation curve. (D) Experimental design of in vitro myeloid differentiation assay and serial replating of wild-type (wt) and Cbfb-MYH11-expressing (CM) BM cells infected with empty (MIG) or Runx2-expressing (Runx2) retrovirus; 104 GFP sorted cells were cultured in methylcellulose. (E) Representative photograph of day 7 CFUs comparing wild-type (top) and Cbfb-MYH11-expressing (bottom) BM cells infected with empty (MIG) or Runx2-expressing (Runx2) retrovirus in plating 1. (F) Histogram showing the number of day 7 myeloid CFU in platings 1 (
) cells by quantitative PCR. Transcripts for total Runx2 (Rx2), P1- or P2-specific, and exon 5-containing (Ex5) isoforms. (C) Relative expression levels of Runx2 (Rx2) and Runx1 (Rx1) in sorted HSCs, CMP, GMP, and MEP cells determined by quantitative PCR and normalized to primer bias using limiting dilution correlation curve. (D) Experimental design of in vitro myeloid differentiation assay and serial replating of wild-type (wt) and Cbfb-MYH11-expressing (CM) BM cells infected with empty (MIG) or Runx2-expressing (Runx2) retrovirus; 104 GFP sorted cells were cultured in methylcellulose. (E) Representative photograph of day 7 CFUs comparing wild-type (top) and Cbfb-MYH11-expressing (bottom) BM cells infected with empty (MIG) or Runx2-expressing (Runx2) retrovirus in plating 1. (F) Histogram showing the number of day 7 myeloid CFU in platings 1 ( ), 2 (■), and 3 (□). Data are mean plus or minus SD from at least 2 independent experiments, each in triplicate.
), 2 (■), and 3 (□). Data are mean plus or minus SD from at least 2 independent experiments, each in triplicate.
Sustained Runx2 expression inhibits myeloid differentiation capacity
We reasoned that the inability to down-regulate Runx2 expression during myeloid differentiation may alter proliferation of differentiation programs and enhance Cbfβ-SMMHC-mediated differentiation block. To test this hypothesis, we asked whether myeloid differentiation is perturbed by sustained expression of Runx2 using an in vitro differentiation and serial replating assay in methylcellulose (Figure 1D). Bone marrow progenitor cells from 5-FU-treated Cbfb+/56M;Mx1Cre mice expressing Cbfβ-SMMHC and wild-type mice were transduced with pMSCV-IRES-GFP (MIG) or MIG-Runx2 retrovirus, and GFP-sorted cells were plated in semisolid methylcellulose cultures. As depicted in Figure 1E, the colony size in Cbfb-MYH11-expressing groups was significantly reduced, with similar average cell number per colony in control MIG and control Runx2 groups, 60% reduced in the Cbfb-MYH11/MIG group and 91.5% reduced in the Cbfb-MYH11/Runx2 group. We found no difference between groups in annexin V/7-amino-actinomycin D staining, suggesting that the difference in colony size was not the result of cell death (data not shown). The number of myeloid CFU in day 7 plates from MIG-Runx2/wt cultures were significantly reduced compared with MIG/wt controls (Figure 1F). The previously observed increase in first plating CFU number because of expression of Cbfb-MYH1134 was also reduced. In addition, Runx2 expression repressed the replating of CFUs in serial replating assays. These results indicate that sustained Runx2 expression hinders myeloid colony-forming capacity, probably because of reduced proliferation or differentiation of Cbfb-MYH11 expressing preleukemic myeloid progenitors.
Runx2 represses expression of CBF targets and committed myeloid markers
Considering that sustained Runx2 expression interferes with myeloid differentiation/proliferation capacity, we asked whether Runx2 expression could alter expression of CBF targets and myeloid marker genes in HP cells. The transcription of myeloperoxidase (Mpo) and colony-stimulating factor 1 receptor (Csf1R) genes is up-regulated by Runx1, whereas transcription of the cell cycle inhibitor Cdkn1A (p21Cip/Waf) gene is inhibited by Runx1 in myeloid progenitors and by Runx2 in osteoblasts.43-46 In addition, expression of the myeloid differentiation marker Cebpd has been reported to be regulated by Runx2 in osteoblasts.47 The expression of CBF-independent myeloid genes Cebpa and Gfi1 was also included to test the alteration of myeloid programs. To estimate the expression of these genes, quantitative PCR was performed using cDNA form GFP-sorted HPs expressing wt-MIG, wt/MIG-Runx2 (wt-Runx2), Cbfb-MYH11/MIG (CM), or Cbfb-MYH11/MIG-Runx2 (CM-Rx2), as shown in Figure 2A. The relative expression levels (RELs) of CBF targets Csf1r, Mpo, and Cebpd were significantly reduced by Runx2 or Cbfβ-SMMHC (Figure 2A left panels). The RELs of myeloid genes Cebpa and Gfi1 were also reduced in cells expressing Runx2. Contrary to these findings, Cdkn1a RELs were increased in cells expressing Cbfβ-SMMHC, an effect that was inhibited by sustained Runx2. In addition, expression of Cdkn1a was partly recovered in the presence of the Runx2 Y418A mutant, a mutation within the NMTS that inhibits binding to the corepressor YAP (Figure 2B). This Runx2 amino acid change was not relevant in repression of Cebpd, suggesting that Y418 residue within the NMTS domain of Runx2 may play a role in repression of genes up-regulated by Cbfβ-SMMHC.
Runx2 overexpression alters expression of CBF targets and myeloid differentiation. (A) RELs of CBF targets Csf1r, Mpo, Cebpd, and Cdkn1a, and myeloid genes Cebpa and Gfi1 in GFP-sorted wt and CM progenitors infected with MIG or Runx2 (Rx2) retrovirus, using quantitative RT-PCR assay. Data are mean plus or minus SD from at least 2 independent experiments, each in triplicate. (B) RELs of CBF targets Cebpd and Cdkn1a, in GFP-sorted wt and CM progenitors infected with MIG, Runx2 (Rx2), or Runx2 Y418A (Y418) mutant retrovirus, using quantitative RT-PCR assay. (C) Chromatin immunoprecipitation assay of cells expressing Runx2 using primers for promoter sequences (horizontal double line) of Csf1r, Mpo, Cebpd, and Cdkn1a (left) with CBF consensus sites (vertical line), and CBF-unrelated control genes Cdc6 and Phox, using anti-Runx2 (■) or anti-IgG antibody. Relative specificity is shown as percentage of input.
Runx2 overexpression alters expression of CBF targets and myeloid differentiation. (A) RELs of CBF targets Csf1r, Mpo, Cebpd, and Cdkn1a, and myeloid genes Cebpa and Gfi1 in GFP-sorted wt and CM progenitors infected with MIG or Runx2 (Rx2) retrovirus, using quantitative RT-PCR assay. Data are mean plus or minus SD from at least 2 independent experiments, each in triplicate. (B) RELs of CBF targets Cebpd and Cdkn1a, in GFP-sorted wt and CM progenitors infected with MIG, Runx2 (Rx2), or Runx2 Y418A (Y418) mutant retrovirus, using quantitative RT-PCR assay. (C) Chromatin immunoprecipitation assay of cells expressing Runx2 using primers for promoter sequences (horizontal double line) of Csf1r, Mpo, Cebpd, and Cdkn1a (left) with CBF consensus sites (vertical line), and CBF-unrelated control genes Cdc6 and Phox, using anti-Runx2 (■) or anti-IgG antibody. Relative specificity is shown as percentage of input.
To test whether Runx2 repression of these genes is a direct Runx2 effect in the promoter of CBF targets, we performed chromatin immunoprecipitation assays. For this experiment, MIG-Runx2/Cbfb-MYH11 leukemic cells were GFP sorted and pooled to obtain sufficient number of cells, and chromatin immunoprecipitation performed using anti-IgG or anti-Runx2 antibody. The amplification of promoter sequence flanking the CBF binding site in the promoter region of Cebpd, Csf1R, Cdkn1a, and Mpo was tested in triplicate and 2 experiments (Figure 2C). In addition, amplification of unrelated Cdc6 promoter and Phox 3′-untranslated region were included as controls. The binding specificity was normalized to the input signal. In support of our hypotheses, these results show that when expressed in myeloid progenitors, Runx2 directly binds and represses myeloid genes regulated by Runx1 or Runx2.
Runx2 cooperates with Cbfβ-SMMHC to induce AML
The Runx2 locus was identified as a common insertion site in a retrovirus insertion mutagenesis screen in mice expressing the leukemia fusion oncogene Cbfb-MYH11.35 The viral insertions in the 3 leukemic samples were mapped within its intron 5 (Figure 3A). Analysis of these AML samples by RT-PCR revealed expression of 3 mRNAs from its proximal promoter P2: a full-length Runx2 mRNA, a truncated mRNA including exons 2 to 5 (RT1), and a truncated mRNA including exons 2 to 4 (RT2). In addition, a truncated Runx2 mRNA initiated form the viral sequence with exons 6 to 8 was detected (RT3; Figure 3A). The truncated mRNAs RT1 and RT2 include the sequence for the RHD and nuclear localization signal, whereas RT3 includes the C-terminal TAD, NMTS, and VWRPY-repression motif. These truncated transcripts were generated as a consequence of the viral insertions because RT1 and RT2 include viral sequence at their 3′ end and RT3 at its 5′ end (Figure 3A black bars). Because the leukemic samples consisted of a mix population of leukemic and nonleukemic cells, we were unable to quantify the relative ratio of these variants in the tumor cells. We therefore tested the transforming capacity of each variant in vivo.
Runx2 cooperates with Cbfβ-SMMHC to induce AML in mice. (A) Depiction of Runx2 transcripts identified in leukemia cells with retrovirus insertions in the intron 5 of Runx2 (arrowheads), the full-length Runx2, and various truncated Runx2 (RT1, RT2, RT3) constructs used in this study. The coding (gray boxes) and noncoding (open boxes) exons, and distal (P1) and proximal (P2) promoters (arrows) are shown on top. The transcripts isolated from leukemic samples for the full-length (Runx2) and truncated RT1, RT2, and RT3 transcripts, including indicated exons (gray lines) and viral sequences (black lines). (B) Western blot analysis showing the expression of full-length Runx2 (lane 1), RT1 (lane 2), and RT-2 (lane 3) from the expression constructs used. (C) BM transduction transplantation strategy for validation of Runx2 oncogenic function. BM progenitors from wild-type or Cbfb-MYH11 (CM) expressing mice were infected with MIG retrovirus and transplanted into irradiated isogenic recipients. Statistical significance was performed using the log-rank test. (D) Kaplan-Meier survival curve of Runx2/CM (n = 22), RT1/CM (n = 12), RT2/CM (n = 10), RT3/CM (n = 8) or mock/CM (n = 24), and Runx2 (n = 11), RT1 (n = 6), RT2 (n = 6), RT3 (n = 6) or mock (n = 6) in wild-type cells. Analysis of statistical significance was performed using the log-rank test. (E) Kaplan-Meier survival curve depicting the role of Runx2 heterozygosity in Cbfβ-SMMHC-mediated leukemogenesis. Test groups included Cbfb+/56MMx1Cre Runx2+/+ mice expressing Cbfb-MYH11 (CM; n = 28), Cbfb+/56MMx1CreRunx2+/− (CM/Rx2+/−, n = 34), and Cbfb+/56MMx1CreRunx2+/dC (CM/RdC; n = 46). Control groups included pIpC-treated Cbfb+/56M (control; n = 15) and untreated Cbfb+/56M/Mx1Cre (control, n = 15) mice. Analysis of statistical significance was performed using the log-rank test.
Runx2 cooperates with Cbfβ-SMMHC to induce AML in mice. (A) Depiction of Runx2 transcripts identified in leukemia cells with retrovirus insertions in the intron 5 of Runx2 (arrowheads), the full-length Runx2, and various truncated Runx2 (RT1, RT2, RT3) constructs used in this study. The coding (gray boxes) and noncoding (open boxes) exons, and distal (P1) and proximal (P2) promoters (arrows) are shown on top. The transcripts isolated from leukemic samples for the full-length (Runx2) and truncated RT1, RT2, and RT3 transcripts, including indicated exons (gray lines) and viral sequences (black lines). (B) Western blot analysis showing the expression of full-length Runx2 (lane 1), RT1 (lane 2), and RT-2 (lane 3) from the expression constructs used. (C) BM transduction transplantation strategy for validation of Runx2 oncogenic function. BM progenitors from wild-type or Cbfb-MYH11 (CM) expressing mice were infected with MIG retrovirus and transplanted into irradiated isogenic recipients. Statistical significance was performed using the log-rank test. (D) Kaplan-Meier survival curve of Runx2/CM (n = 22), RT1/CM (n = 12), RT2/CM (n = 10), RT3/CM (n = 8) or mock/CM (n = 24), and Runx2 (n = 11), RT1 (n = 6), RT2 (n = 6), RT3 (n = 6) or mock (n = 6) in wild-type cells. Analysis of statistical significance was performed using the log-rank test. (E) Kaplan-Meier survival curve depicting the role of Runx2 heterozygosity in Cbfβ-SMMHC-mediated leukemogenesis. Test groups included Cbfb+/56MMx1Cre Runx2+/+ mice expressing Cbfb-MYH11 (CM; n = 28), Cbfb+/56MMx1CreRunx2+/− (CM/Rx2+/−, n = 34), and Cbfb+/56MMx1CreRunx2+/dC (CM/RdC; n = 46). Control groups included pIpC-treated Cbfb+/56M (control; n = 15) and untreated Cbfb+/56M/Mx1Cre (control, n = 15) mice. Analysis of statistical significance was performed using the log-rank test.
Considering that the RUNX factors have been implicated in leukemia as either tumor suppressors or oncogenes, the genetic data led us to test 4 alternative hypotheses: (1) expression of the full-length Runx2 accelerates myeloid leukemia transformation; (2) the RT1 and RT2 truncated Runx2 proteins tightly bind to DNA, acting as a dominate-negative Runx factor; (3) the RT3 truncated form sequesters cofactors form the target genes, inducing transformation; and (4) the viral insertion renders a null allele, and Runx2 haploinsufficiency induces AML. The cDNA fragments for RT1, RT2, and RT3 were isolated from tumor samples and cloned into MIG vectors. The expression of RT1 and RT2 was confirmed by Western blot analysis (Figure 3B). Expression of RT3 was not included because the Runx2 antibody does not recognizes the C-terminal region. The first 3 hypotheses were tested using BM transduction-transplantation assays (Figure 3C) in Cbfb+/56M;Mx1Cre (CM) or wild-type BM transduced with retrovirus expressing full-length Runx2 or truncated Runx2 sequences RT1, RT2, or RT3. All mice transplanted with Runx2/CM progenitor cells (n = 22) developed myeloid leukemia with a median latency of 17 weeks (range, 7-27 weeks, P = 3.02e−12; Figure 3D solid line). Conversely, all mice transplanted with RT1/CM (n = 12), RT2/CM (n = 10), RT3/CM (n = 8), and control groups with MIG/CM (n = 22), Runx2/wt (n = 11), RT1/wt (n = 6), RT-2/wt (n = 6), RT-3/wt (n = 6), or MIG/wt (n = 6) remained healthy for 24 weeks (experimental endpoint).
To test whether haploinsufficiency of Runx2, as a result of the viral insertion in intron 5, may enhance Cbfb-MYH11-mediated leukemogenesis, we generated Cbfb+/56M;Mx1Cre;Runx2+/− mice with a Runx2-null allele.8 Alternatively, we generated Cbfb+/56M;Mx1Cre; Runx2+/ΔC (CM/RΔC) mice harboring a C-terminal truncated Runx2 protein that lacks the NMTS and TAD and is unable to localize in the nuclear bodies.36 All mice were treated with 3 doses of pIpC at 4 to 6 weeks of age to induce Cbfb-MYH11 expression. The Cbfb+/56M;Mx1Cre (CM) mice developed AML with a median latency of 20 weeks (range, 12-27 weeks; Figure 3E thin dotted lane) as previously reported.34 The Cbfb+/56M;Mx1Cre;Runx2+/− (CM/Rx2+/−) mice developed leukemia with reduced penetrance of 60% (Figure 3E dashed line; P = 3.43e−05), and significant delay in the leukemia onset and latency compared with Cbfb+/56M;Mx1Cre;Runx2+/+ mice (median latency = 38 weeks, P = 2.6e−10). Similar results were observed in Cbfb+/56M /Mx1Cre/Runx2+/ΔC (CM/RΔC) mice with a median latency of 32 weeks and a 60% leukemia penetrance (Figure 3E solid line, P = 1.03e−05), and significant delay in leukemia development compared with Cbfb+/56M;Mx1Cre;Runx2+/+ mice (P = 7.3e−08). The kinetics of disease latency and onset between Runx2+/ΔC- and Runx2+/−-expressing groups was not significant (P = .51), indicating that both Runx2 mutations have similar effect in Cbfβ-SMMHC–mediated leukemia. To verify the malignant nature of the disease, BM cells from affected mice were transplanted into sublethally irradiated recipients (n = 12). In all cases, the disease was readily reproduced with a median latency of 5 weeks (data not shown).
The pathology of leukemia in mice with Cbfb-MYH11 and Runx2 expressing AML cells included leukocytosis, anemia, splenomegaly, and infiltration in multiple organs, such as spleen and liver (Figure 4Ai,ii). Enlargement of thymus and lymph nodes was not observed in affected mice, indicating a nonlymphoid leukemia (data not shown). Cytologic analysis of peripheral blood from sick mice showed a predominant blastlike population (Figure 4Aiv arrowhead) and a minor immature-monocytic population (Figure 4Aiv arrow). Immunophenotypic analysis of peripheral blood cells showed that the AML cells are predominantly c-kit+ and Lin− (Lin: Mac1, Gr1, CD3, B220, Ter119; Figure 4B). This pathology was characteristic of all groups, supporting the idea that the pathology of leukemia is directed by the expression of Cbfb-MYH11. In addition, Runx2-induced leukemic cells were consistently GFP+, confirming the expression of the retrovirus. Finally, the expression of Cbfb-MYH11 and Runx2 in AML cells was confirmed by RT-PCR and quantitative PCR (data not shown). Together, these results show that sustained expression of Runx2 enhances Cbfβ-SMMHC–mediated AML development.
Leukemic cells are predominantly blastlike and Lin−Kit+. (A) Hematoxylin and eosin–stained histology sections of spleen (i), liver (ii), and BM (iii) from Runx2-induced leukemic mice. Wright-Giemsa staining of peripheral blood (iv) showing a predominant blastlike population ( ) and a monocytic population (
) and a monocytic population ( ). (B) FACS analysis of GFP (expressed from MSCV-iresGFP), lineage markers (Gr1, Mac1, B220, CD3, Ter119), and progenitor marker (c-Kit) in spontaneous leukemia (top) and 2 Runx2-induced leukemia (R2-7, R2-3, middle and bottom).
). (B) FACS analysis of GFP (expressed from MSCV-iresGFP), lineage markers (Gr1, Mac1, B220, CD3, Ter119), and progenitor marker (c-Kit) in spontaneous leukemia (top) and 2 Runx2-induced leukemia (R2-7, R2-3, middle and bottom).
Leukemic cells are predominantly blastlike and Lin−Kit+. (A) Hematoxylin and eosin–stained histology sections of spleen (i), liver (ii), and BM (iii) from Runx2-induced leukemic mice. Wright-Giemsa staining of peripheral blood (iv) showing a predominant blastlike population ( ) and a monocytic population (
) and a monocytic population ( ). (B) FACS analysis of GFP (expressed from MSCV-iresGFP), lineage markers (Gr1, Mac1, B220, CD3, Ter119), and progenitor marker (c-Kit) in spontaneous leukemia (top) and 2 Runx2-induced leukemia (R2-7, R2-3, middle and bottom).
). (B) FACS analysis of GFP (expressed from MSCV-iresGFP), lineage markers (Gr1, Mac1, B220, CD3, Ter119), and progenitor marker (c-Kit) in spontaneous leukemia (top) and 2 Runx2-induced leukemia (R2-7, R2-3, middle and bottom).
The leukemogenic function of Runx2 requires a transcriptionally active protein
The finding that a full-length Runx2 but not the truncated proteins containing the DNA-binding domain induces AML led us to reason that Runx2 may transcriptionally regulate a subset of genes that requires functional RHD for DNA-binding and TAD (Figure 5A). Alternatively, Runx2 may act to sequester regulatory cofactors away from transcription machinery and not require functional RHD and TAD. To address these hypotheses, we tested the leukemogenic functions of 3 Runx2 mutants using BM transduction/transplantation assays. Retroviruses expressing mutant Runx2 included R217Q, a point mutation in the RHD that hinders DNA-binding ability while maintaining intact its folding and binding to Cbfβ.48 In addition, we created Runx2 mutants carrying the Y418A and HTY411AAA mutations within the NMTS, mutations that have been shown to disrupt binding to coregulatory factors YAP and SMAD, respectively.49-51 Expression of the Runx2 mutants was confirmed by Western blot analysis (Figure 5B). The Runx2 oncogenic capacity was completely abolished in the R217Q mutant mice (n = 7) over the 24 weeks after transplantation (Figure 5C). Notably, recipients transplanted with NMTS mutations Y418A (n = 8) and HTY (n = 8) developed leukemia with significantly delayed onset (16 and 22 weeks; both cases with P < 1e−04) and reduced penetrance (20%-25%; P = .03 and P = .04, respectively) compared with MIG-Runx2–transduced group (Figure 5C). These results demonstrate that functional RHD and NMTS domains are critical for Runx2-mediated AML development.
Functional DNA-binding and transactivation domains of Runx2 are required to induce AML in cooperation with Cbfβ-SMMHC. (A) Depiction of point mutants R217Q (in DNA-binding RHD), Y418A, and HTY (within NMTS) used in this study. (B) Western blot analysis showing the expression of wild-type Runx2 (lane 1), R217Q (lane 2), Y418A (lane 3), and HTY (lane 4) from the constructs used in this study. (C) Kaplan-Meier survival curve of mice transplanted with cells expressing Cbfβ-SMMHC and wild-type Runx2 (thick solid line, n = 22), R217Q (thin dashed line, n = 7), Y418A (gray dashed line, n = 8), HTY (thick dashed line, n = 8), or mock (thin solid line, n = 24). Analysis of statistical significance was performed using the log-rank test.
Functional DNA-binding and transactivation domains of Runx2 are required to induce AML in cooperation with Cbfβ-SMMHC. (A) Depiction of point mutants R217Q (in DNA-binding RHD), Y418A, and HTY (within NMTS) used in this study. (B) Western blot analysis showing the expression of wild-type Runx2 (lane 1), R217Q (lane 2), Y418A (lane 3), and HTY (lane 4) from the constructs used in this study. (C) Kaplan-Meier survival curve of mice transplanted with cells expressing Cbfβ-SMMHC and wild-type Runx2 (thick solid line, n = 22), R217Q (thin dashed line, n = 7), Y418A (gray dashed line, n = 8), HTY (thick dashed line, n = 8), or mock (thin solid line, n = 24). Analysis of statistical significance was performed using the log-rank test.
Discussion
Alteration in the expression and function of CBFs plays an important role in cancer development, including leukemias.9 Genetic studies in mice have identified the Runx2 locus as a candidate leukemia gene in mice expressing Cbfb-MYH11,35 NUP98-HOXD13,52 and Myc.26 This study demonstrates that sustained Runx2 expression induces myeloid leukemia in synergy with CBFβ-SMMHC and that expression of myeloid genes and the cell cycle inhibitor Cdkn1a is repressed during transformation.
The expression of the leukemia fusion MLL-AF9 in committed GMPs induces transformation and reactivates an 11 gene-set “self-renewal” signature that included Runx2.53 Sustained Runx2 expression induces lymphoid leukemia in cooperation with Myc.26 Accordingly, we show that expression of full-length Runx2, and not the truncated forms, promotes myeloid malignancy. It is possible that the proviral LTR may interfere with the activity of the Runx2 promoter and/or other cis-acting elements, such as a conserved element with SMAD-, CBF-, and Hox-consensus binding sites, predicted within the RUNX2 intron 6.54 In addition, Runx2 haplo-insufficiency delays and reduces CBFβ-SMMHC–induced leukemia, further supporting that the levels of Runx2 expression can modulate the leukemogenic function of CBFβ-SMMHC.
We have previously found that loss of Cbfβ expression accelerates CBFβ-SMMHC-leukemia.55 The possibility that Runx2 may act by tittering Cbfβ or other cofactors from promoter regions is doubtful because DNA binding is critical for transformation. The binding of Runx2 to DNA seems to be required as R217Q Runx2 mutant is unable to trigger malignancy, and we did detect Runx2 binding to CBF targets in the AML cells. Another important domain for its oncogenic role is the NMTS region. The PPY-motif mediates binding of the corepressor YAP, and Runx2/YAP interaction is critical for Runx2-induced transformation in vitro.56,57 In line with this idea, we showed that oncogenic role of Runx2 is abrogated in Runx2(Y418A) mutant, suggesting that the Runx2/YAP interaction participates in leukemia transformation. In addition, the residues HTY participate in Runx2/Smad interaction. The HTYL-to-AAAL substitution abrogates this interaction and Runx2 recruitment to the nuclear matrix and to chromatin. We found that Runx2/Smad-deficient Runx2 (HTY411AAA) mutants were unable to produce leukemia, highlighting the participation of these interactions in the Runx2 oncogenic role. Of note, other Runx2 corepressors, such as the histone deacetylaces HDAC6 and HDAC7, also interact with Runx2 in this region,46,58 suggesting the involvement of HDACs in leukemogenesis.
The expression of cell-cycle inhibitor p21Cip/waf is repressed by Runx1 and Runx245,46 and induced by CBF fusion protein AML1-ETO in HPs. However, p21Cip/waf is not expressed in CBF AML cells. It was recently shown that AML1-ETO–induced disease is accelerated in Cdkn1a-null mice,59 suggesting that inhibition of p21 expression is a required step during CBF-induced leukemia development. In line with this idea, we find that Cbfβ-SMMHC induces Cdkn1a expression in HPs and that this activation is reversed by Runx2. Moreover, R217Q or Y418A mutations significantly reduce the ability of Runx2 to repress Cdkn1a expression. These results provide a probable mechanistic insight into the role of Runx2 in leukemia transformation.
We have found that endogenous Runx2 expression peaks in HSCs/early HPs (LSK compartment), with higher transcript levels than Runx1. The Runx2 levels were similar between early LSK-FLT3− and later LSK-FLT3+ subcompartments (data not shown), and decrease progressively in CMPs and committed progenitors. Similarly, Runx2 levels are reduced during T-cell development, and sustained Runx2 expression alters normal T-cell development at the T-cell receptor-β selection stage by altering Runx1 regulation within this compartment.60,61 It is therefore probable that Runx1 and Runx2 coregulate CBF targets in early HPs, including the HSCs. Our data suggest that failure to reduce Runx2 levels may hinder the ability of myeloid progenitors to differentiate in vitro and repress expression of myeloid genes and that reduction in Runx2 levels observed in CMPs and later progenitors seems critical for normal myelopoiesis. We have found that Runx2 binds to promoters of CBF targets Mpo, Csf1r, Cdkn1a, and Cebpd and represses their expression. Thus, highlighting that sustained Runx2 expression directly represses, at least some, CBF targets in primary HPs and leukemic cells.
This study demonstrates that regulation of RUNX2 expression is critical for normal hematopoiesis and myeloid malignancy and suggests that up-regulated expression may suppress activation of targets by other Runx proteins, disrupting differentiation programs and promoting transformation.
The publication costs of this article were defrayed in part by page charge payment. Therefore, and solely to indicate this fact, this article is hereby marked “advertisement” in accordance with 18 USC section 1734.
Acknowledgments
The authors thank Julie Zhu for statistical analysis of the data.
This work was supported by National Institutes of Health (Bethesda, MD; grant CA096983; L.H.C.). Y.-H.K. was supported by the Ruth L. Kirschstein National Research Service Award (F32CA101571). L.H.C. is a Scholar of the Leukemia & Lymphoma Society (White Plains, NY).
National Institutes of Health
Authorship
Contribution: Y.-H.K. designed and performed experiments, analyzed experimental results, and participated in writing of the manuscript; S.K.Z. participated in the design of experiments, performed experiments, and helped in the writing of the manuscript; S.G. performed experiments and participated in the preparation of the manuscript; T.K. provided the Runx2 knockout mice and participated in the writing of the manuscript; G.S.S. provided the Runx2+/ΔC mice and participated in the writing of the manuscript; and L.H.C. participated in the design and interpretation of the experiments and the writing of the manuscript.
Conflict-of-interest disclosure: The authors declare no competing financial interests.
Correspondence: Lucio H. Castilla, Program in Gene Function and Expression, University of Massachusetts Medical School, 364 Plantation St, LRB Rm 622, Worcester, MA 01605; e-mail: Lucio.Castilla@umassmed.edu.

), CMP (□), GMP (■), and MEP (
), CMP (□), GMP (■), and MEP ( ) cells by quantitative PCR. Transcripts for total Runx2 (Rx2), P1- or P2-specific, and exon 5-containing (Ex5) isoforms. (C) Relative expression levels of Runx2 (Rx2) and Runx1 (Rx1) in sorted HSCs, CMP, GMP, and MEP cells determined by quantitative PCR and normalized to primer bias using limiting dilution correlation curve. (D) Experimental design of in vitro myeloid differentiation assay and serial replating of wild-type (wt) and Cbfb-MYH11-expressing (CM) BM cells infected with empty (MIG) or Runx2-expressing (Runx2) retrovirus; 104 GFP sorted cells were cultured in methylcellulose. (E) Representative photograph of day 7 CFUs comparing wild-type (top) and Cbfb-MYH11-expressing (bottom) BM cells infected with empty (MIG) or Runx2-expressing (Runx2) retrovirus in plating 1. (F) Histogram showing the number of day 7 myeloid CFU in platings 1 (
) cells by quantitative PCR. Transcripts for total Runx2 (Rx2), P1- or P2-specific, and exon 5-containing (Ex5) isoforms. (C) Relative expression levels of Runx2 (Rx2) and Runx1 (Rx1) in sorted HSCs, CMP, GMP, and MEP cells determined by quantitative PCR and normalized to primer bias using limiting dilution correlation curve. (D) Experimental design of in vitro myeloid differentiation assay and serial replating of wild-type (wt) and Cbfb-MYH11-expressing (CM) BM cells infected with empty (MIG) or Runx2-expressing (Runx2) retrovirus; 104 GFP sorted cells were cultured in methylcellulose. (E) Representative photograph of day 7 CFUs comparing wild-type (top) and Cbfb-MYH11-expressing (bottom) BM cells infected with empty (MIG) or Runx2-expressing (Runx2) retrovirus in plating 1. (F) Histogram showing the number of day 7 myeloid CFU in platings 1 (


 ) and a monocytic population (
) and a monocytic population ( ). (B) FACS analysis of GFP (expressed from MSCV-iresGFP), lineage markers (Gr1, Mac1, B220, CD3, Ter119), and progenitor marker (c-Kit) in spontaneous leukemia (top) and 2 Runx2-induced leukemia (R2-7, R2-3, middle and bottom).
). (B) FACS analysis of GFP (expressed from MSCV-iresGFP), lineage markers (Gr1, Mac1, B220, CD3, Ter119), and progenitor marker (c-Kit) in spontaneous leukemia (top) and 2 Runx2-induced leukemia (R2-7, R2-3, middle and bottom).